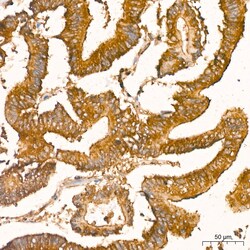
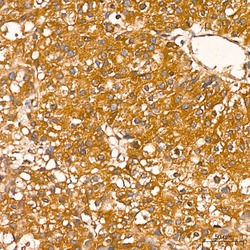

MA5-51360
antibody from Invitrogen Antibodies
Targeting: RELA
NFKB3, p65
 Western blot
Western blot ELISA
ELISA Immunocytochemistry
Immunocytochemistry Immunoprecipitation
Immunoprecipitation Immunohistochemistry
Immunohistochemistry Chromatin Immunoprecipitation
Chromatin ImmunoprecipitationAntibody data
- Antibody Data
- Antigen structure
- References [0]
- Comments [0]
- Validations
- Western blot [2]
- Immunocytochemistry [1]
- Immunohistochemistry [3]
- Chromatin Immunoprecipitation [1]
Submit
Validation data
Reference
Comment
Report error
- Product number
- MA5-51360 - Provider product page

- Provider
- Invitrogen Antibodies
- Product name
- NFkB p65 Recombinant Rabbit Monoclonal Antibody (6D6R8)
- Antibody type
- Monoclonal
- Antigen
- Synthetic peptide
- Description
- Immunogen sequence: LGALLGNSTD PAVFTDLASV DNSEFQQLLN QGIPVAPHTT EPMLMEYPEA ITRLVTGAQR PPDPAPAPLG APGLPNGLLS GDEDFSSIAD MDFSALLSQI SS
- Reactivity
- Human, Mouse, Rat
- Host
- Rabbit
- Isotype
- IgG
- Antibody clone number
- 6D6R8
- Vial size
- 100 μL
- Concentration
- 1 mg/mL
- Storage
- -20°C, Avoid Freeze/Thaw Cycles
No comments: Submit comment
Supportive validation
- Submitted by
- Invitrogen Antibodies (provider)
- Main image

- Experimental details
- Western blot analysis of NFkB p65 in extracts from wild type(WT) and NF-kB p65/RelA knockout (KO) HeLa cells. Samples were incubated with NFkB p65 Recombinant monoclonal antibody (Product # MA5-51360) using a dilution of 1:10,000 followed by HRP Goat Anti-Rabbit IgG (H+L) secondary antibody at a dilution of 1:10,000. Lysates/proteins: 25 µg per lane. Blocking buffer: 3% nonfat dry milk in TBST. Detection: ECL Basic Kit. Exposure time: 10s.
- Submitted by
- Invitrogen Antibodies (provider)
- Main image

- Experimental details
- Western blot analysis of NFkB p65 in extracts of various cell lines. Samples were incubated with NFkB p65 Recombinant monoclonal antibody (Product # MA5-51360) using a dilution of 1:10,000 followed by HRP Goat Anti-Rabbit IgG (H+L) secondary antibody at a dilution of 1:10,000. Lysates/proteins: 25 µg per lane. Blocking buffer: 3% nonfat dry milk in TBST. Detection: ECL Basic Kit. Exposure time: 30s.
Supportive validation
- Submitted by
- Invitrogen Antibodies (provider)
- Main image

- Experimental details
- Immunocytochemistry (confocal imaging) analysis of NFkB p65 in HeLa cells. Samples were incubated with NFkB p65 Recombinant monoclonal antibody (Product # MA5-51360) using a dilution of 1:100 (Red). The cells were counterstained with Monomethyl-HistoneH3-K4 Rabbit mAb (dilution 1:300) (Green). DAPI was used for nuclear staining (blue). Objective: 60x.
Supportive validation
- Submitted by
- Invitrogen Antibodies (provider)
- Main image
- Experimental details
- Immunohistochemistry analysis of NFkB p65 in paraffin-embedded human colon carcinoma. Samples were incubated with NFkB p65 Recombinant monoclonal antibody (Product # MA5-51360) using a dilution of 1:200 (40x lens). Perform high pressure antigen retrieval with 10 mM citrate buffer pH 6.0 before commencing with IHC staining protocol.
- Submitted by
- Invitrogen Antibodies (provider)
- Main image

- Experimental details
- Immunohistochemistry analysis of NFkB p65 in paraffin-embedded human liver. Samples were incubated with NFkB p65 Recombinant monoclonal antibody (Product # MA5-51360) using a dilution of 1:200 (40x lens). Perform high pressure antigen retrieval with 10 mM citrate buffer pH 6.0 before commencing with IHC staining protocol.
- Submitted by
- Invitrogen Antibodies (provider)
- Main image
- Experimental details
- Immunohistochemistry analysis of NFkB p65 in paraffin-embedded human liver. Samples were incubated with NFkB p65 Recombinant monoclonal antibody (Product # MA5-51360) using a dilution of 1:200 (40x lens). Perform high pressure antigen retrieval with 10 mM citrate buffer pH 6.0 before commencing with IHC staining protocol.
Supportive validation
- Submitted by
- Invitrogen Antibodies (provider)
- Main image

- Experimental details
- ChIP assay of NFkB p65 in HT-1080 cells treated by TNF alpha (20 ng/mL) at 37°C for 30 minutes. Samples were incubated with NFkB p65 Recombinant monoclonal antibody (Product # MA5-51360) with rabbit IgG. The amount of immunoprecipitated DNA was checked by quantitative PCR. Histogram was constructed by the ratios of the immunoprecipitated DNA to the input.
 Explore
Explore Validate
Validate Learn
Learn